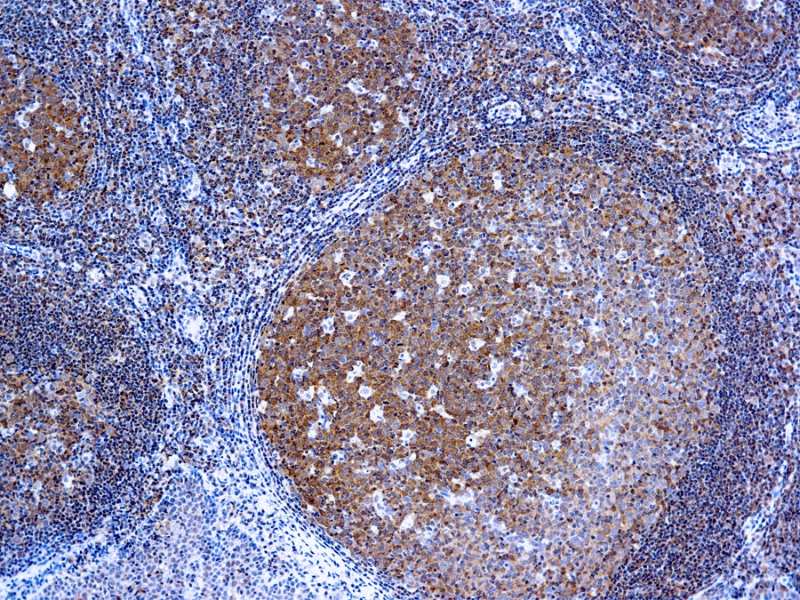

Antigen Background
Monoclonal anti-bcl-10 reacts specifically with human bcl-10. The epitope recognized by the antibody resides within amino acids 122-168 of human bcl-10 molecule. Bcl-10, also designated as CIPER, mE10, cE10, CARMEN, and CLAP, is an N-terminal CARD (caspase recruitment domain) containing protein.
It is a cellular homologue of the equine herpesvirus-2 protein E-10 (vCLAP). Bcl-10 was implicated in the regulation of apoptosis by interacting with caspase 9, enhancing procaspase 9 processing, and triggering its activation when overexpressed in the cell. Bcl-10 cellular overexpression induces JNK, p38, and NF-kB activation. Deregulation of bcl-10 expression was also demonstrated to be involved in cellular oncogenesis.
0.5ml
| Clone | 151 |
| Isotype | IgG1 |
| Application | IHC |
La documentazione sarà disponibile a breve, nel frattempo potete contattarci via mail a specialist@histoline.com